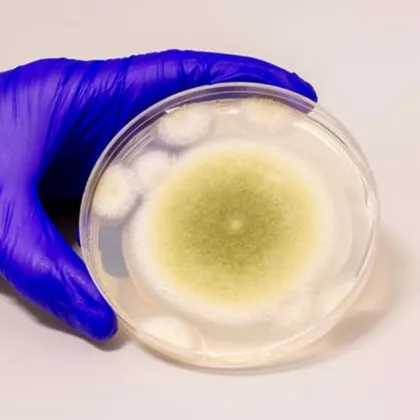
Изследователи са използвали смъртоносна гъба Aspergillus flavus за да създадат

... (освен ако не е специално пречистена козметична кал), тъй като солите могат да раздразнят очите и устните.Гениталната област.Открити рани, изгаряния или екземи в остра фаза.
Може Лекува - Новини
Софийската градска прокуратура поиска най тежката мярка за неотклонение за Никола
...... дървениците".Пред съда самият Паскал, заяви:"Искам по-лека мярка за неотклонение, за да си направя операция в Германия“.По-късно днес се очаква да стане ясно решението на съда.
BOTOX е лечение на заден ход Поклонниците на това лечение
...... посветените казват, че победите надвишават вълненията. Разгледайте повече Внимавайте тези 5 признака на „силно инвазивен“ рак на мозъка - пациентите обикновено преживяват само 15 месеца
Пациентите с диабет тип 1 имат реален шанс да се
...... към масовата му употреба все още не е завършен, за първи път медицината разполага с инструмент за потенциално излекуване, а не само за доживотен контрол.
В неочакван обрат в борбата срещу рака обикновени кухненски бактерии
...... тези, които помагат на раковите клетки да растат и да оцеляват. Този двоен удар забавя прогресията на рака и насърчава злокачествените клетки да се самоубиват.
Мигренозната аура може да се прояви като зрителни нарушения често
...... за облекчаване на симптомите помагат за намаляване на тежестта на предстоящ мигренозен пристъп. Те обикновено се приемат веднага щом започнат симптомите на аура или продром.
Изследователи от Калифорнийския университет в Дейвис създадоха нова версия на
...... могат да станат основа за нова вълна от ефективни и по-безопасни терапии в психиатрията – без да е нужно пациентите да „пътуват“ в други измерения.
Тази минимална промяна е имала огромен ефект вместо да предизвиква
...... могат да станат основа за нова вълна от ефективни и по-безопасни терапии в психиатрията – без да е нужно пациентите да „пътуват“ в други измерения.
Изследователи са използвали смъртоносна гъба Aspergillus flavus за да създадат
...... да се тестват асперигимицини върху животински модели, с крайна цел клинични изпитвания върху хора.Превод: GlasNews.bg / Снимка: Проба от Aspergillus flavus, култивирана в лабораторията Gao / Bella Ciervo
Чернодробните заболявания са все по голям проблем за здравето засягащ милиони
...... по-ефективното ѝ лечение в бъдеще. Засега здравословните навици и ранните мерки остават най-добрите начини да се грижите за черния си дроб и цялостното си здраве.
Невроинтерфейсът отчита и стимулира мозъка в 16 точки едновременно И
...... Компанията очаква първите прототипи да се появят в края на 2025 г. и в момента активно търси партньори, желаещи да интегрират разработката в своите проекти.
Възраждане отново избухнаха с поредна малоумна акция Голям вой че
...... за ЮНЕСКО И УНИЦЕФ не може!!!Наистина трябва да се въведе тест за интелигентност за депутатите и тези с едноцифрен КИ да не бъдат допускани!Елена Гунчева-Гривова
да видят всички теми Връзка копирана Следвайте Изследователите описаха случая
...... пресечени през следващите пет до 10 години. Тогава цялото поле ще се движи като блок, защото сме доста готови." Вижте всички теми Връзка копирана! Следвайте
Бебе родено с рядко и опасно генетично заболяване расте и
...... здраве и наука в Асошиейтед прес получава подкрепа от Фондацията на науката на медицинския институт на Хауърд Хюс. AP е единствено отговорен за цялото съдържание.
Ново изследване на рака създадено от мемориалния кеттеринг на Слоан
...... за 4/20 - Време е да се запасите CBD за 4/20? Тествахме най -добрите гуми и повече, така че не е нужно да топ концерти
Учени откриха в ново проучване че яденето на един фъстък
...... фъстъчено масло или фъстъчени продукти. В края на проучването две трети от участниците са в състояние да изядат пет фъстъка, без да реагират, допълва БТА
Наистина в съвременната урология и медицина се наблюдава значителна промяна
...... бъбреците, често при деца). Причината може да се крие и в сексуално предавани инфекции, например, хламидия, гонорея; атрофичен вагинит при жени след менопауза", каза урологът.
Лимонът – полезен цитрус но не е панацея срещу ракаЛимонът
...... от всякога да подхождаме критично към здравните съвети, които циркулират в социалните мрежи. Консултацията с квалифицирани медицински специалисти остава най-надеждният път към правилните здравословни решения.
Смятам че наредбата е непълна и регистърът трябва да публичен
...... решение. Това се случва в детска възраст, понякога в семейството, понякога извън, но всички насилници преди това са били жертви на насилие", обясни Тодор Тодоров.
Смятам че наредбата е непълна и регистърът трябва да публичен
...... решение. Това се случва в детска възраст, понякога в семейството, понякога извън, но всички насилници преди това са били жертви на насилие", обясни Тодор Тодоров.
Добре знаем колко е важен качественият сън както за физическото
...... тази страна, от която е болката. И не по-малко важно е да спим достатъчно, за да може по-бързо да се справим с инфекциите и възпаленията.
Добре знаем колко е важен качественият сън както за физическото
...... тази страна, от която е болката. И не по-малко важно е да спим достатъчно, за да може по-бързо да се справим с инфекциите и възпаленията.
Възможно ли е от собствената ни кръв да бъде създаден
...... се да поддържаме това, което природата и нашето тяло вече правят. Работим с тялото ни и затова наричаме този материал биокооперативен", каза професорът. бТВ, „Тази събота"
Възможно ли е от собствената ни кръв да бъде създаден
...... този материал биокооперативен“, каза професорът.Целия разговор вижте във видеото.Последвайте ни за още актуални новини в Google News ShowcaseПоследвайте btvnovinite.bg във VIBERПоследвайте btvnovinite.bg в INSTAGRAMПоследвайте btvnovinite.bg във FACEBOOK Продължи да четеш
Арттерапията е разновидност на психотерапията която използва средствата на изкуството за
...... визуално-пластичните и кинетичните изкуства като: Рисуване; Гравиране; Печат; Живописни техники; Акварел; Пастел; Масло; Темпера; Колаж; Техники на моделиране; Точене; Формуване; Валиране; Конструиране; Прибавяне и отнемане.
Спреят за нос е одобрен в САЩ и е препоръчан
...... последното тримесечие на 2024 г.За повече информация относно тази история гледайте видеоклипа в медийния плейър по-горе.Видео редактор • Roselyne MinОтидете на преките пътища за достъпност
Вещество открито в паразитна гъба може да се превърне в
...... от гъба, която расте върху гъсеници, а защо не и да се превърне от древно лекарство до най-модерната терапия за лечение на рак, предаде bTV.
Вещество открито в паразитна гъба може да се превърне в
...... растеж, които са свръхактивни при рака, той може да остави здравите клетки почти незасегнати за разлика от традиционните методи за лечение. Продължи да четеш
Под номер 6 в предаването Пееш или лъжеш беше представена
...... печелила много награди."Наистина съм лауреат на много национални и световни конкурси. Тази година ще бъда 12-ти клас и се подготвям за медицинския университет", каза участничката.
Отровата от подобни на стоножки същества намерени в подводните пещери на мексиканския полуостров
...... само поради неговото екологично значение, но и поради потенциалните вещества, които могат да бъдат от решаващо значение за нас, хората“, казва д-р фон Реумонт.Превод: GlasNews.bg
Главният изпълнителен директор на OpenAI Сам Алтман каза че новото
...... да отговаря на заявки, но и да решава задачи на ниво автономно мислене, което през следващите години отваря огромни възможности за научни и технологични иновации.
Скорошно проучване проведено в Мичиганския държавен университет е установило че
...... и облекчаването на симптомите му след приложение на плацебо. Подобрението на симптоматиката се дължи на очаквания ефект от терапията, а не на самата терапия.Снимка: Depositphotos.com
Рекламите на три марки добавки които твърдяха че помагат при
...... да гарантира, че бъдещата им реклама не твърди, че храната в тези случаи под формата на. добавка може да предотврати, лекува или излекува човешки заболявания.
Робин Алдерман е изправена пред агонизираща реалност генната терапия може
...... и наука на Асошиейтед прес получава подкрепа от науката на медицинския институт Хауърд Хюз и Образователна медийна група. AP е единствено отговорен за цялото съдържание.
Родопската песен е изградена върху един специфичен лад пентатоника конструиран
...... песен да бъде изпратена в космоса. Според певицата има само още три държави, които имат такава пентатонична основа в музиката си: Япония, Китай и Тибет.
Тревога сред децата родителите и лекарите първи смъртни случаи
...... на това заболяване да се помогне на хората за по-лесна диагностика. Това ще бъде улеснение и за нас да ограничим заразата“, посочи д-р Деница Даскалова.
Бележка на редактора Джейсън Момоа е актьор и глобален защитник
...... насочват гласовете ни? Моят призив към нашето поколение е да прегърнем и да се застъпим за възстановяването на природата и да започнем да правим вълни.
Лечението на болката в мозъка не е лесно тъй като
...... разлика в качеството на живот или до възможност за справяне с хроничната болка с лекарства без рецепта вместо с опиоиди, отпускани с рецепта", твърди Легон./БГНЕС
Когато крал Чарлз беше коронясан най големият му син принц Уилям
...... краля, голямата операция на Кейт, която я държеше далеч от официални задължения до след Великден, и диагнозата рак на кожата на Сара, херцогинята на Йорк.
Болестите се лекуват с мисъл Мисълта може да изпъди всяка
...... приятна и той от ден на ден се усеща все по-добре, по-разположен. Тогава всички здрави хора ще почнат да посещават този човек. Петър Дънов инфо:
Без реформи в здравеопазването ще има елит който може да
...... да го мислят и с опасяват, че това ще им навреди на следващите избори,“ отбеляза още изпълнителният директор на CredoWeb и здравен журналист Петър Галев.
Активното вещество силденафил което откриваме във виаграта би могло да
...... белите дробове. Най-вероятно този медикамент може да помогне и при много други медицински състояния (не само при мегахранопровод), съобщава IFLScience, цитирано от "Обекти". Последвайте канала на
Въпреки напредъка в лечението на депресията и други терапии за
...... съединение. „Това е особено важно да се подчертае, като се има предвид нарастващото присъствие на незаконно, но открито продаван псилоцибин в големите градове.“
Докато опиоидната епидемия продължава да бушува някои защитници в Кентъки
...... били достатъчни, за да позволят клиничните изпитвания при пациенти в Кентъки да започнат веднага. Ако не, изследователите може да се наложи да започнат с nonhuma
Докато костни увреждания като например фрактури обикновено заздравяват сами големи
...... си дебелина и произведоха нови кръвоносни съдове". Такъв не е бил случаят с контролите, което показва, че триизмерният хидрогел наистина е отговорен за резултата. Източник: New Atlas
Британско американският журналист и телевизионен оператор Луис Теру сподели че губи
...... за себе си и психологическата подкрепа също могат да бъдат важни, тъй като алопецията може да има значително емоционално и психологическо въздействие за много хора.
От десетилетия ядрената медицина спасява човешки животи като дава възможност
...... на проект, наречен MicroNOVA. Ако всичко върви по план, технологията може да постави началото на нова ера в лечението на рак и производството на медицински изотопи.